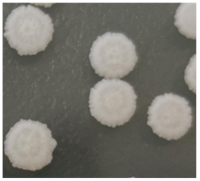
Fermentation 09 00303 i003

Effects of Mixed Fermentation on the Aroma Compounds of ‘Italian Riesling’ Dry White Wine in Eastern Foothill of Helan Mountain
Abstract
1. Introduction
2. Materials and Methods
2.1. Grapes
2.2. Strains and Media
2.3. Fermentation Strategies
2.4. Activation Culture of Strain
2.5. Yeast Count
2.6. Basic Oenological Parameters Analysis
2.7. Volatile Analysis
2.8. Sensory Analysis
2.9. Statistical Analysis
3. Results and Discussion
3.1. Analysis of Alcohol Fermentation Rate
3.2. Growth Kinetics of Yeast Strains during Fermentations
3.3. Wine Characteristics
3.4. Volatile Aroma Compounds after Alcoholic Fermentation
3.5. Sensory Evaluation of Wine
4. Discussion
5. Conclusions
Author Contributions
Funding
Data Availability Statement
Conflicts of Interest
References
- González, R.; Morales, P. Truth in wine yeast. Microb. Biotechnol. 2022, 15, 1339–1356. [Google Scholar] [CrossRef]
- Swiegers, J.; Pretorius, I. Yeast modulation of wine flavor. Adv. Appl. Microbiol. 2005, 57, 131–175. [Google Scholar] [CrossRef] [PubMed]
- Padilla, B.; Gil, J.; Manzanares, P. Past and future of non-Saccharomyces yeasts: From spoilage microorganisms to biotechnological tools for improving wine aroma complexity. Front. Microbiol. 2016, 7, 411–441. [Google Scholar] [CrossRef] [PubMed]
- Tufariello, M.; Fragasso, M.; Pico, J.; Panighel, A.; Castellarin, S.D.; Flamini, R.; Grieco, F. Influence of non-Saccharomyces on wine chemistry: A focus on aroma-related compounds. Molecules 2021, 26, 644. [Google Scholar] [CrossRef] [PubMed]
- Pretorius, I.S. Tailoring wine yeast for the new millennium: Novel approaches to the ancient art of winemaking. Yeast 2000, 16, 675–729. [Google Scholar] [CrossRef] [PubMed]
- Ciani, M.; Comitini, F.; Mannazzu, I.; Domizio, P. Controlled mixed culture fermentation: A new perspective on the use of non-Saccharomyces yeasts in winemaking. Fems Yeast Res. 2010, 10, 123–133. [Google Scholar] [CrossRef]
- Amerine, M.A.; Cruess, W.V. The Technology of Winemaking; The AVI Publishing Company Inc.: Westport, CT, USA, 1960. [Google Scholar]
- Castelli, T. Yeasts of Wine Fermentation from Various Regions of Italy. Am. J. Enol. Vitic. 1955, 6, 18–20. Available online: http://www.ajevonline.org/content/6/1/18.abstract (accessed on 6 September 2022).
- Snow, P.G.; Gallander, J.F. Deacidification of white table wines through partial fermentation with Schizosaccharomyces pombe. Am. J. Enol. Vitic. 1979, 5, 30. [Google Scholar] [CrossRef]
- Mora, J.; Barbas, J.I.; Mulet, A. Growth of yeast species during the fermentation of musts inoculated with Kluyveromyces thermotolerans and Saccharomyces cerevisiae. Am. J. Enol. Vitic. 1990, 41, 156–159. [Google Scholar] [CrossRef]
- Kapsopoulou, K.; Mourtzini, A.; Anthoulas, M.; Nerantzis, E. Biological acidification during grape must fermentation using mixed cultures of Kluyveromyces thermotolerans and Saccharomyces cerevisiae. World J. Microbiol. Biotechnol. 2007, 23, 735–739. [Google Scholar] [CrossRef]
- Morata, A.; Escott, C.; Bañuelos, M.A.; Loira, I.; Del Fresno, J.M.; González, C.; Suárez-Lepe, J.A. Contribution of Non-Saccharomyces Yeasts to Wine Freshness. A Review. Biomolecules 2019, 1, 10. [Google Scholar] [CrossRef]
- Moreira, N.; Mendes, F.; de Pinho, P.G.; Hogg, T.; Vasconcelos, I. Heavy sulphur compounds, higher alcohols and esters production profile of Hanseniaspora uvarum and Hanseniaspora guilliermondii grown as pure and mixed cultures in grape must. Int. J. Food Microbiol. 2008, 124, 231–238. [Google Scholar] [CrossRef]
- Anfang, N. Co-Fermentation with Pichia kluyveri Increases Varietal Thiol Concentrations in Sauvignon Blanc. Aust. J. Grape Wine Res. 2010, 15, 1–8. Available online: https://www.sogou.com/link?url=B7ss7T7Ay4kC7X4DDEhltwybn6D-nIJZdsJrVXvavWmx5Y89wnL07w (accessed on 12 September 2022). [CrossRef]
- Varela, C.; Barker, A.; Tran, T.; Borneman, A.; Curtin, C. Sensory profile and volatile aroma composition of reduced alcohol Merlot wines fermented with Metschnikowia pulcherrima and Saccharomyces uvarum. Int. J. Food Microbiol. 2017, 252, 1–9. [Google Scholar] [CrossRef] [PubMed]
- Marcon, A.R.; Schwarz, L.V.; Dutra, S.V.; Moura, S.; Agostini, F.; Delamare, A.P.L.; Echeverrigaray, S. Contribution of a Brazilian Torulaspora delbrueckii isolate and a commercial Saccharomyces cerevisiae to the aroma profile and sensory characteristics of Moscato Branco wines. Aust. J. Grape Wine Res. 2018, 24, 461–468. [Google Scholar] [CrossRef]
- Hu, K.; Jin, G.J.; Mei, W.C.; Li, T.; Tao, Y.S. Increase of medium-chain fatty acid ethyl ester content in mixed H. uvarum/S. cerevisiae fermentation leads to wine fruity aroma enhancement. Food Chem. 2018, 239, 495–501. [Google Scholar] [CrossRef] [PubMed]
- Tristezza, M.; Tufariello, M.; Capozzi, V.; Spano, G.; Mita, G.; Grieco, F. The oenological potential of Hanseniaspora uvarum in simultaneous and sequential co-fermentation with Saccharomyces cerevisiae for industrial wine production. Front. Microbiol. 2016, 7, 670–684. [Google Scholar] [CrossRef] [PubMed]
- Wang, Q.Q.; Qin, J.; Ma, C.; Tao, Y.S. Pichia yeast and S. cerevisiae mixed fermentation are preferred to make Egory dry white wine. Chin. Agric. Sci. 2018, 51, 2178–2192. (In Chinese) [Google Scholar]
- Zuo, J.W.; Qi, X.Y.; Zhao, C.Y.; Zhang, J.X.; Xue, J. Aroma composition analysis of Chardonnay and Italian Riesling dry white wines in the eastern foot of Helan Mountain, Ningxia. Food Ferment. Ind. 2016, 42, 149–155. (In Chinese) [Google Scholar]
- Hu, K.; Jin, G.J.; Xu, Y.H.; Tao, Y.S. Wine aroma response to different participation of selected Hanseniaspora uvarum in mixed fermentation with Saccharomyces cerevisiae. Food Res. Int. 2018, 108, 119–127. [Google Scholar] [CrossRef]
- Li, N.; Wang, Q.Q.; Xu, Y.H.; Li, A.H.; Tao, Y.S. Increased glycosidase activities improved the production of wine varietal odorants in mixed fermentation of P. fermentans and high antagonistic S. cerevisiae. Food Chem. 2020, 332, 127426. [Google Scholar] [CrossRef] [PubMed]
- Yang, X.; Su, L.; Liu, S.W. The WL Nutrient Medium Was Used to Identify the Associated Yeast Species in Wine. Chin. Foreign Grapes Wine 2006, 4, 4–7. (In Chinese). Available online: https://kns.cnki.net/kcms2/article/abstract?v=8pLOALknL0b9SW0MoJZZLRO-83UG6PqUQEepqBC7Y8GTCaitIG3ub3B07TZFOiBYU9jwEjzVJ5tttMp5YX-Tiyi5yLETuDX70Mh0NK1B5__OjpwFUXWwDg==&uniplatform=NZKPT&language=CHS (accessed on 3 October 2022).
- Yang, Y.; Xu, Y.W.; Xue, J.X.; Liu, Y.L. Validation of the Identification Effect of WL Trophic Agar on Wine-Associated Yeast. J. Microbiol. 2007, 5, 75–78. (In Chinese). Available online: https://kns.cnki.net/kcms2/article/abstract?v=8pLOALknL0a9BdsEjJuM8DyThdQnYc9G_AZHGsbR7EIuQneG4-clKIz4WwJ5aKlnLDysSx3SF1VT5YwMC1YRM86R1T9pm25hz6h_DqGria6agkRIBswULw==&uniplatform=NZKPT (accessed on 13 September 2022).
- Pallmann, C.L.; Brown, J.A. Use of WL Medium to Profile Native Flora Fermentations. Am. J. Enol. Vitic. 2001, 52, 198–203. [Google Scholar] [CrossRef]
- Shen, J.Y.; Liu, P.; Duan, C.Q.; Yan, G.L. Effect of mixed fermentation of different yeast and S. cerevisiae on the aroma of Vidal ice wine. Food Ferment. Ind. 2017, 43, 16–23. (In Chinese) [Google Scholar]
- GB/T 15038-2006; General Analysis Method for Wine and Fruit Wine. Standardization Administration of China: Beijing, China, 2006.
- Bai, X.; King, K.; Liu, S.; Ma, W.; Zhang, Z.; Wang, H.Q.; Zhang, J.X. The fermentation properties of Q19 and its effect on wine aroma composition at low temperatures. Food Sci. 2020, 41, 146–152. (In Chinese) [Google Scholar]
- Zellner, B.D.A.; Bicchi, C.; Dugo, P.; Rubiolo, P.; Dugo, G.; Mondello, L. Linear retention indices in gas chromatographic analysis: A review. Flavour Fragr. J. 2008, 23, 297–314. [Google Scholar] [CrossRef]
- Zhang, Z.; Li, H.; Zhang, J.; Xue, J.; Zhang, J. Aroma Characteristics of ‘Cabernet Sauvignon’ Dry Red Wine at the Eastern Foothill of Helan Mountain. Food Sci. 2019, 40, 203–209. (In Chinese). Available online: http://kns.cnki.net/kcms/detail/11.2206.TS.20190102.1530.115.html (accessed on 13 September 2022).
- Barbará, J.A.; Nicolli, K.P.; Souza-Silva, É.A.; Biasoto, A.C.T.; Welke, J.E.; Zini, C.A. Volatile profile and aroma potential of tropical Syrah wines elaborated in different maturation and maceration times using comprehensive two-dimensional gas chromatography and olfactometry. Food Chem. 2020, 308, 252–256. [Google Scholar]
- Zhu, X.; Liu, Q.; Zhao, D.; Duan, W.P.; Han, S.; Liang, X.S. Optimization of the brewing process parameters of dry white wine. J. Agric. Eng. 2019, 35, 10. [Google Scholar]
- Roubelakis-Angelakis, K.A. Grapevine Molecular Physiology & Biotechnology; Springer Netherlands: Berlin/Heidelberg, Germany, 2009. [Google Scholar] [CrossRef]
- Tao, Y.; Zhang, L. Intensity prediction of typical aroma characters of cabernet sauvignon wine in Changli County (China). Food Sci. Technol. 2010, 43, 1550–1556. [Google Scholar] [CrossRef]
- Cai, J.; Zhu, B.-Q.; Wang, Y.-H.; Lu, L.; Lan, Y.-B.; Reeves, M.J.; Duan, C.-Q. Influence of pre-fermentation cold maceration treatment on aroma compounds of Cabernet Sauvignon wines fermented in different industrial scale fermenters. Food Chem. 2014, 154, 217–229. [Google Scholar] [CrossRef] [PubMed]
- Wang, X.-J.; Tao, Y.-S.; Wu, Y.; An, R.-Y.; Yue, Z.-Y. Aroma compounds and characteristics of noble-rot wines of Chardonnay grapes artificially botrytized in the vineyard. Food Chem. 2017, 226, 41–50. [Google Scholar] [CrossRef] [PubMed]
- Culleré, L.; Escudero, A.; Cacho, J.; Ferreira, V. Gas Chromatography−Olfactometry and Chemical Quantitative Study of the Aroma of Six Premium Quality Spanish Aged Red Wines. J. Agric. Food Chem. 2004, 52, 1653–1660. [Google Scholar] [CrossRef] [PubMed]
- Wang, J.; Capone, D.L.; Wilkinson, K.L.; Jeffery, D.W. Chemical and sensory profiles of rosé wines from Australia. Food Chem. 2015, 196, 682–693. [Google Scholar] [CrossRef] [PubMed]
- Loira, I.; Morata, A.; Comuzzo, P.; Callejo, M.J.; González, C.; Calderón, F.; Suárez-Lepe, J.A. Use of Schizosaccharomyces pombe and Torulaspora delbrueckii strains in mixed and sequential fermentations to improve red wine sensory quality. Food Res. Int. 2015, 76, 325–333. [Google Scholar] [CrossRef] [PubMed]
- Zhang, W.J.; Yang, S.; Du, S.; Jiang, J.; Ye, D.Q.; Liu, Y. L Analysis of flavor enhancing potential of hybrid fermentation of local Pichia kluyveri and Saccharomyces cerevisiae. Food Sci. 2020, 41, 84–90. (In Chinese) [Google Scholar]
- Belda, I.; Ruiz, J.; Esteban-Fernández, A.; Navascués, E.; Marquina, D.; Santos, A.; Moreno-Arribas, M.V. Microbial Contribution to Wine Aroma and Its Intended Use for Wine Quality Improvement. Molecules 2017, 22, 189. [Google Scholar] [CrossRef]
- Wang, C.; Mas, A.; Esteve-Zarzoso, B. Interaction between Hanseniaspora uvarum and Saccharomyces cerevisiae during alcoholic fermentation. Int. J. Food Microbiol. 2015, 206, 67–74. [Google Scholar] [CrossRef]
- Bordet, F.; Joran, A.; Klein, G.; Roullier-Gall, C.; Alexandre, H. Yeast–Yeast Interactions: Mechanisms, Methodologies and Impact on Composition. Microorganisms 2020, 8, 600. [Google Scholar] [CrossRef]
- Nissen, P.; Nielsen, D.; Arneborg, N. Viable Saccharomyces cerevisiae cells at high concentrations cause early growth arrest of non-Saccharomyces yeasts in mixed cultures by a cell-cell contact-mediated mechanism. Yeast 2003, 20, 331–341. [Google Scholar] [CrossRef]
- Molina, A.M.; Swiegers, J.H.; Varela, C.; Pretorius, I.; Agosin, E. Influence of wine fermentation temperature on the synthesis of yeast-derived volatile aroma compounds. Appl. Microbiol. Biotechnol. 2007, 77, 675–687. [Google Scholar] [CrossRef]
- Bell, S.-J.; Henschke, P.A. Implications of nitrogen nutrition for grapes, fermentation and wine. Aust. J. Grape Wine Res. 2005, 11, 242–295. [Google Scholar] [CrossRef]
- Domizio, P.; Romani, C.; Lencioni, L.; Comitini, F.; Gobbi, M.; Mannazzu, I.; Ciani, M. Outlining a future for non-Saccharomyces yeasts: Selection of putative spoilage wine strains to be used in association with Saccharomyces cerevisiae for grape juice fermentation. Int. J. Food Microbiol. 2011, 147, 170–180. [Google Scholar] [CrossRef]
- Rivas, G.A.; Guillade, A.C.; Semorile, L.C.; Delfederico, L. Influence of Climate on Soil and Wine Bacterial Diversity on a Vineyard in a Non-traditional Wine Region in Argentina. Front. Microbiol. 2021, 12, 726384. [Google Scholar] [CrossRef]
- Furlani, M.V.M.; Maturano, Y.P.; Combina, M.; Mercado, L.A.; Toro, M.E.; Vazquez, F. Selection of non-Saccharomyces yeasts to be used in grape musts with high alcoholic potential: A strategy to obtain wines with reduced ethanol content. FEMS Yeast Res. 2017, 17, 11–16. [Google Scholar] [CrossRef]
- Ciani, M.; Morales, P.; Comitini, F.; Tronchoni, J.; Canonico, L.; Curiel, J.A.; Oro, L.; Rodrigues, A.J.; Gonzalez, R. Non-conventional Yeast Species for Lowering Ethanol Content of Wines. Front. Microbiol. 2016, 7, 642. [Google Scholar] [CrossRef]
- You, Y.; Duan, C.Q.; Yan, G.L. Effects of mixed fermentation of Candida humilis and Saccharomyces cerevisiae on ethanol content and aroma of wine. Food Sci. 2018, 39, 157–165. (In Chinese) [Google Scholar]
- Contreras, A.; Hidalgo, C.; Schmidt, S.; Henschke, P.; Curtin, C.; Varela, C. The application of non-Saccharomyces yeast in fermentations with limited aeration as a strategy for the production of wine with reduced alcohol content. Int. J. Food Microbiol. 2015, 205, 7–15. [Google Scholar] [CrossRef] [PubMed]
- Benito, S.; Hofmann, T.; Laier, M.; Lochbühler, B.; Schüttler, A.; Ebert, K.; Fritsch, S.; Röcker, J.; Rauhut, D. Effect on quality and composition of Riesling wines fermented by sequential inoculation with non-Saccharomyces and Saccharomyces cerevisiae. Eur. Food Res. Technol. 2015, 241, 707–717. [Google Scholar] [CrossRef]
- Capece, A.; Fiore, C.; Maraz, A.; Romano, P. Molecular and technological approaches to evaluate strain biodiversity in Hanseniaspora uvarum of wine origin. J. Appl. Microbiol. 2004, 98, 136–144. [Google Scholar] [CrossRef] [PubMed]
- Clemente-Jimenez, J.; Mingorance-Cazorla, L.; Martínez-Rodríguez, S.; Heras-Vázquez, F.L.; Rodríguez-Vico, F. Influence of sequential yeast mixtures on wine fermentation. Int. J. Food Microbiol. 2005, 98, 301–308. [Google Scholar] [CrossRef] [PubMed]



| Strain Number | Species | Colony Color [24] | Colony Features [24,25] | Colony Map |
|---|---|---|---|---|
| Excellence TXL | Saccharomyces cerevisiae | Cream, ribbon green | Specular protrusion, smooth, regular surface, and opaque | ![]() |
| Yun268 | Hanseniaspora uvarum | Bottle green | Flat, smooth, opaque, and oily | ![]() |
| Z9Y-3 | Pichia fermentans | Cream | Indicating wrinkled and opaque, serrated edges, round | ![]() |
| Fermentation Step | Fermentation Strategies |
|---|---|
| Step1 | The grape was crushed and pressed to extract the juice in a ton-controlled temperature fermenter (50 mg/L SO2, 20 mg/L pectinase was added). |
| Step2 | Adding 1.0 g/L bentonite and 100 mg/L PVPP for clarification treatment. |
| Step3 | Impregnating at low temperature (4 °C) for 24 h, then separating the clarification juice in a 5 L glass fermenter. Finally, return temperature to 18 °C. |
| Step4 | The yeast was inoculated according to different groups. A total of eight experimental treatments were set up (Table 2). |
| Step5 | The temperature was controlled at 18–22 °C for alcohol fermentation. Determined the specific gravity of grape juice every two days in the fermentation process. |
| Step6 | Added 60 mg/L SO2 at the end of fermentation and transferred the wine into a clean and hygienic 5 L glass jar for sealed storage. |
| Step7 | Carried out normal clarification and stability before bottling for storage. The wine was analyzed a month later. |
| Control | Mixed Fermentation | |||||||
|---|---|---|---|---|---|---|---|---|
| S.cerevisiae | H. uvarum & S.cerevisiae | P. fermentans & S.cerevisiae | ||||||
| CK S. cerevisiae was inoculated alone | WCH1 simultaneous Inoculation, (1:1) | WCH10 simultaneous Inoculation, (10:1) | WSH1 Sequential inoculation, (1:1) | WSH10 Sequential inoculation, (10:1) | WCP1 simultaneous inoculation, (1:1) | WCP10 simultaneous Inoculation, (10:1) | WSP1 Sequential inoculation, (1:1) | WSP10 Sequential inoculation (10:1) |
| Parameters | Control | Hanseniaspora uvarum | Pichia fermentans | ||||||
|---|---|---|---|---|---|---|---|---|---|
| CK | WSH1 | WSH10 | WCH1 | WCH10 | WSP1 | WSP10 | WCP1 | WCP10 | |
| Ethanol (% vol) | 12.32 ± 0.08 a | 11.95 ± 0.03 b | 11.65 ± 0.03 de | 12.06 ± 0.01 b | 11.74 ± 0.09 cd | 11.8 ± 0.06 c | 11.61 ± 0.02 e | 11.96 ± 0.02 b | 11.79 ± 0.02 c |
| Residual sugar (g/L) | 2.88 ± 0.18 b | 3.25 ± 0 ab | 3.13 ± 0.18 ab | 3.13 ± 0.18 ab | 2.38 ± 0.18 c | 3 ± 0 ab | 2.88 ± 0.18 b | 3.38 ± 0.18 a | 2.88 ± 0.18 b |
| Titratable acidity (g/L) | 4.99 ± 0.26 ab | 5.17 ± 0 ab | 5.36 ± 0.26 a | 4.8 ± 0 b | 5.17 ± 0 ab | 5.17 ± 0 ab | 4.99 ± 0.26 ab | 5.17 ± 0 ab | 5.36 ± 0.26 a |
| pH | 3.65 ± 0.01 b | 3.54 ± 0.01 e | 3.51 ± 0.01 f | 3.69 ± 0.01 a | 3.54 ± 0.01 e | 3.54 ± 0.01 e | 3.63 ± 0.01 c | 3.56 ± 0.01 d | 3.52 ± 0.01 f |
| Glycerol (g/L) | 7.35 ± 0.01 f | 7.63 ± 0.01 de | 7.68 ± 0.02 c | 7.6 ± 0.02 e | 7.73 ± 0 b | 7.78 ± 0.03 a | 7.82 ± 0.01 a | 7.66 ± 0.01 cd | 7.73 ± 0.02 b |
| Volatile acidity (g/L) | 0.28 ± 0.02 f | 0.51 ± 0.02 b | 0.66 ± 0.02 a | 0.29 ± 0.03 f | 0.43 ± 0.01 c | 0.33 ± 0 e | 0.37 ± 0.01 de | 0.33 ± 0.01 e | 0.38 ± 0.01 d |
| Number | Compound | Aroma Substance Concentration (mg/L) | The Threshold Value (mg/L) | Aroma Description [17,18,20,34,35,36,37,38,39,40,41] | ||||||||
|---|---|---|---|---|---|---|---|---|---|---|---|---|
| CK | WSH1 | WSH10 | WCH1 | WCH10 | WSP1 | WSP10 | WCP1 | WCP10 | ||||
| Variety aroma | ||||||||||||
| A1 | 1-Hexanol | 0.67 ± 0.04 d | 0.68 ± 0.14 d | 0.69 ± 0.05 d | 0.87 ± 0.01 abc | 0.96 ± 0.04 a | 0.82 ± 0.07 abcd | 0.73 ± 0.01 cd | 0.77 ± 0.03 bcd | 0.9 ± 0.08 ab | 8 [18] | Flowers, fruity, green grass |
| A2 | Tert-hexadothiol | 0 ± 0 e | 0.01 ± 0 c | 0.02 ± 0 a | 0.01 ± 0 d | 0.02 ± 0 b | 0 ± 0 e | 0 ± 0 e | 0 ± 0 e | 0 ± 0 e | NF | NF |
| A3 | β-damasone | 0.23 ± 0.01 d | 0.23 ± 0.01 d | 0.53 ± 0.01 b | 0.41 ± 0.04 c | 0.3 ± 0.07 d | 0.22 ± 0.05 d | 0.5 ± 0.02 b | 0.53 ± 0.02 b | 0.74 ± 0.02 a | 0.05 [19] | Sweet apples, plums, and canned peaches |
| A4 | 2,4-di-tert-butylphenol | 0.01 ± 0 b | 0.22 ± 0.02 ab | 0.53 ± 0.38 a | 0.64 ± 0.33 a | 0.38 ± 0.04 ab | 0.2 ± 0.06 ab | 0.28 ± 0.07 ab | 0.34 ± 0 ab | 0.26 ± 0.15 ab | 0.2 [34] | NF |
| A5 | Linalool | 0.05 ± 0.01 e | 0.06 ± 0.01 d | 0.07 ± 0 abc | 0.06 ± 0 d | 0.07 ± 0 ab | 0.06 ± 0 cd | 0.07 ± 0 a | 0.07 ± 0 bc | 0.07 ± 0 a | 0.025 [35] | Flowers, musk, lavender incense |
| Total | 0.96 ± 0.05 d | 1.2 ± 0.15 cd | 1.84 ± 0.42 ab | 1.98 ± 0.36 a | 1.73 ± 0.15 ab | 1.31 ± 0.07 bcd | 1.58 ± 0.08 abc | 1.71 ± 0.01 abc | 1.98 ± 0.21 a | |||
| Fermented aroma | ||||||||||||
| Higher alcohols | 182.85 ± 5.89 d | 201.66 ± 4 bc | 198 ± 5.33 bcd | 203.76 ± 13.28 bc | 190.24 ± 10.55 cd | 209.03 ± 0.13 b | 239.58 ± 3.76 a | 164.62 ± 9.89 e | 200.69 ± 4.53 bcd | |||
| B1 | Isobutanol | 0.53 ± 0.02 e | 0.72 ± 0.04 c | 0.75 ± 0.03 bc | 0.81 ± 0.03 ab | 0.76 ± 0.03 bc | 0.61 ± 0.01 d | 0.87 ± 0 a | 0.77 ± 0.01 bc | 0.81 ± 0.05 ab | 40 [36] | Fusel, alcohol, light sweet |
| B2 | Isoamylol | 153.71 ± 5.62 b | 161.11 ± 1.48 ab | 158.91 ± 5.13 ab | 158.28 ± 10.98 ab | 155.16 ± 12.32 ab | 165.01 ± 3.22 ab | 170.21 ± 3.08 a | 118.41 ± 4.13 c | 159.49 ± 4.11 ab | 30 [19] | Alcohol taste, bitter taste, and nail polish |
| B3 | 2,3-Butanediol | 0.24 ± 0.01 e | 0.29 ± 0.01 e | 0.41 ± 0.03 d | 0.42 ± 0.01 cd | 0.74 ± 0 a | 0.49 ± 0.05 c | 0.6 ± 0.05 b | 0.48 ± 0 cd | 0.72 ± 0.05 a | 120 [36] | Rubber, cream |
| B4 | Phenethyl alcohol | 27.46 ± 0.28 e | 38.53 ± 2.35 bc | 36.91 ± 0.31 cd | 43.13 ± 2.35 bc | 32.41 ± 1.89 de | 42.06 ± 3.07 bc | 66.84 ± 0.71 a | 44.06 ± 5.75 b | 38.81 ± 0.38 bc | 14 [17] | Honey, rose, lilacs |
| B5 | Dodecanol | 0.58 ± 0.01 c | 0.82 ± 0.18 ab | 0.89 ± 0.05 a | 0.82 ± 0 ab | 0.97 ± 0.07 a | 0.67 ± 0.07 bc | 0.86 ± 0.04 a | 0.64 ± 0.01 c | 0.68 ± 0.06 bc | 1 [17] | Floral |
| B6 | Nonanol | 0.32 ± 0 a | 0.19 ± 0.02 c | 0.13 ± 0 d | 0.29 ± 0.01 ab | 0.2 ± 0.02 b | 0.19 ± 0 c | 0.2 ± 0.01 c | 0.27 ± 0.01 b | 0.19 ± 0.01 c | 0.6 [34] | Herbaceous, roses, oranges |
| Ester | 230.42 ± 3.46 e | 272.48 ± 20.63 cd | 271.23 ± 6.92 cd | 276.4 ± 0.91 c | 269.09 ± 3.44 cd | 321.45 ± 0.53 b | 344.28 ± 3.31 a | 257.15 ± 5.58 d | 360.45 ± 1.08 a | |||
| Acetate ester | 45.44 ± 1.41 de | 55.37 ± 1.26 ab | 55.1 ± 0.46 ab | 49.34 ± 1.46 cd | 55.22 ± 0.24 ab | 45.04 ± 5.04 de | 56.75 ± 0.02 a | 42.26 ± 0.71 e | 51.11 ± 2.1 bc | |||
| C1 | Ethyl acetate | 5.65 ± 0.08 c | 8.26 ± 0.07 a | 8.37 ± 0.16 a | 8.06 ± 0 a | 8.23 ± 0.07 a | 6.6 ± 0.3 b | 7.05 ± 0.27 b | 5.31 ± 0.06 c | 6.73 ± 0.36 b | 7.5 [26] | Fruity, sweet taste, and nail polish |
| C2 | Isobutyl acetate | 0.16 ± 0.01 cd | 0.21 ± 0 abc | 0.22 ± 0.02 ab | 0.2 ± 0.01 abc | 0.2 ± 0 abc | 0.17 ± 0.05 bcd | 0.13 ± 0.02 d | 0.13 ± 0.01 d | 0.23 ± 0.02 a | 1.6Aroma of Six | Fruity, pear, banana |
| C3 | Isoamyl acetate | 23.49 ± 2.24 ab | 27.11 ± 0.26 a | 26.93 ± 0.27 a | 23.73 ± 0.69 ab | 26.05 ± 0.41 a | 19 ± 4.52 c | 24.46 ± 0.74 ab | 21.13 ± 0.11 bc | 23.73 ± 1.22 ab | 0.03 [19] | Fruity, fresh banana |
| C4 | Hexyl acetate | 6.44 ± 0.21 c | 8.13 ± 0.19 a | 8.35 ± 0.08 a | 7.25 ± 0.27 b | 8.1 ± 0.02 a | 6.74 ± 0.41 bc | 8.08 ± 0.6 a | 5.67 ± 0.07 d | 7.93 ± 0.34 a | 1.5 [17] | Fruit fragrance, pear, cherry |
| C5 | Heptyl acetate | 0.07 ± 0.01 c | 0.12 ± 0.01 a | 0.13 ± 0.02 a | 0.1 ± 0.01 b | 0.12 ± 0 a | 0.05 ± 0 cd | 0.11 ± 0.01 ab | 0.04 ± 0 d | 0.04 ± 0.01 d | NF | Cherry, pear |
| C6 | Octyl acetate | 0.15 ± 0 cd | 0.18 ± 0.01 b | 0.18 ± 0 b | 0.11 ± 0.01 ef | 0.11 ± 0.01 ef | 0.13 ± 0.01 de | 0.22 ± 0.02 a | 0.1 ± 0.02 f | 0.17 ± 0.01 bc | NF | NF |
| C7 | Phenylethyl acetate | 9.48 ± 0.71 d | 11.35 ± 1.24 bc | 10.91 ± 0.04 bcd | 9.89 ± 1.01 cd | 12.41 ± 0.61 b | 12.35 ± 0.25 b | 16.7 ± 1.09 a | 9.87 ± 0.43 cd | 12.28 ± 0.19 b | 1.5 [17] | Floral, wood |
| Ethyl ester | 173.7 ± 2.03 d | 204.04 ± 17.44 c | 202.16 ± 6.17 c | 211.28 ± 1.2 c | 203.94 ± 3.43 c | 258.65 ± 4.69 b | 264.98 ± 3.27 b | 201.04 ± 4.43 c | 290.62 ± 0.28 a | |||
| D1 | Ethyl butyrate | 0.5 ± 0.02 c | 0.66 ± 0.04 b | 0.6 ± 0.02 bc | 0.64 ± 0.03 b | 0.83 ± 0.01 a | 0.49 ± 0.04 c | 0.66 ± 0.11 b | 0.64 ± 0.02 b | 0.68 ± 0.05 b | 0.02 [17] | Strawberries, apples, bananas |
| D2 | Ethyl hexylate | 35.37 ± 0.64 d | 43.11 ± 3.17 abc | 38.47 ± 0.68 cd | 46.46 ± 1.34 a | 45.91 ± 1.71 a | 40.18 ± 2.39 bcd | 43.9 ± 3.88 ab | 41.99 ± 0.93 abc | 44.75 ± 1.75 ab | 0.014 [18] | Green apple, fruity, strawberry |
| D3 | Ethyl oenanthate | 0.07 ± 0.01 d | 0.07 ± 0.01 cd | 0.08 ± 0.01 bcd | 0.1 ± 0 b | 0.12 ± 0.02 a | 0.08 ± 0 bcd | 0.09 ± 0.01 ab | 0.08 ± 0.01 bcd | 0.07 ± 0 d | 0.22 [17] | Pineapple, fruity |
| D4 | Ethyl caprylate | 44.69 ± 1.01 cd | 50.37 ± 8.63 bc | 45.43 ± 2.53 cd | 45 ± 0.61 cd | 43.08 ± 0.72 cd | 54.5 ± 1.43 ab | 59.2 ± 1.09 a | 37.73 ± 1.67 d | 59.79 ± 1.37 a | 0.005 [39] | Pineapple, pear, floral |
| D5 | Ethyl pelargonate | 0.35 ± 0.02 f | 0.44 ± 0.07 de | 0.39 ± 0.03 ef | 0.59 ± 0.04 bc | 0.5 ± 0.03 cd | 0.6 ± 0.01 b | 0.74 ± 0.03 a | 0.31 ± 0.04 f | 0.51 ± 0.03 bcd | 1. 2 [38] | Fruity, rose, wax, rum |
| D6 | Ethyl caprate | 45.4 ± 1.26 b | 46.06 ± 3.75 b | 47.92 ± 2.83 b | 45.6 ± 0.22 b | 43.19 ± 0.06 b | 54.97 ± 0.99 a | 58.72 ± 0.84 a | 37.08 ± 0.99 c | 58.98 ± 2.85 a | 0.2 [19] | Fruity, fat, wax |
| D7 | Ethyl succinate | 0.26 ± 0 f | 0.25 ± 0.02 f | 0.41 ± 0 e | 0.41 ± 0.04 e | 0.6 ± 0.01 a | 0.54 ± 0.02 b | 0.43 ± 0.01 de | 0.5 ± 0.05 bc | 0.47 ± 0.01 cd | 0.1 [20] | NF |
| D8 | Ethyl 9-decenoate | 20.85 ± 1.15 d | 28.13 ± 0.79 a | 27.48 ± 0.28 ab | 27.04 ± 0.87 ab | 26.84 ± 1.12 ab | 22.6 ± 2.52 cd | 28.72 ± 2.05 a | 27.02 ± 0.02 ab | 24.72 ± 0.63 bc | 0.1 [34] | Fruity |
| D9 | Ethyl laurate | 25.89 ± 0.45 g | 34.31 ± 2.48 f | 40.7 ± 0.36 ef | 44.47 ± 1.31 e | 42.45 ± 3.4 e | 82.74 ± 7.22 b | 70.55 ± 0.79 c | 54.28 ± 0.45 d | 99.03 ± 1.27 a | 1.5 [35] | Sweet, floral, fruitt, creamy |
| D10 | Ethyl myristate | 0.22 ± 0.04 de | 0.44 ± 0.06 cde | 0.52 ± 0.05 cde | 0.62 ± 0.02 bcde | 0.14 ± 0.02 e | 1.1 ± 0 ab | 1.2 ± 0.04 a | 0.72 ± 0.1 abcd | 0.91 ± 0.62 abc | NF | NF |
| D11 | Ethyl palmitate | 0.1 ± 0.01 c | 0.2 ± 0.09 bc | 0.18 ± 0.01 bc | 0.36 ± 0.04 b | 0.26 ± 0.02 bc | 0.86 ± 0.01 a | 0.78 ± 0.06 a | 0.69 ± 0.24 a | 0.73 ± 0.16 a | 1.5 [34] | NF |
| Other esters | 11.28 ± 0.02 e | 13.07 ± 1.93 d | 13.97 ± 0.29 d | 15.78 ± 0.65 c | 9.93 ± 0.23 e | 17.77 ± 0.18 b | 22.55 ± 0.01 a | 13.84 ± 0.44 d | 18.72 ± 0.74 b | |||
| E1 | Methyl caproate | 0.07 ± 0.01 bc | 0.09 ± 0.02 b | 0.07 ± 0.01 bc | 0.08 ± 0.02 b | 0.05 ± 0 c | 0.07 ± 0.01 bc | 0.09 ± 0.02 b | 0.13 ± 0 a | 0.09 ± 0 b | NF | NF |
| E2 | Methyl caprylate | 2.4 ± 0.03 de | 2.48 ± 0.36 cde | 2.47 ± 0.09 cde | 2.94 ± 0 b | 0.5 ± 0.02 f | 2.66 ± 0.18 bcd | 3.66 ± 0.22 a | 2.09 ± 0.05 e | 2.84 ± 0.12 bc | 0.2 [38] | Citrus |
| E3 | Amyl hexylate | 0.87 ± 0.01 de | 1.05 ± 0.14 bcd | 0.84 ± 0.04 e | 1.15 ± 0.12 b | 0.81 ± 0.06 e | 1.07 ± 0.02 bc | 1.42 ± 0.05 a | 0.91 ± 0.02 cde | 1.13 ± 0.15 b | NF | Apple, pineapple |
| E4 | Propyl octanoate | 0.33 ± 0.01 cd | 0.54 ± 0.1 ab | 0.37 ± 0.04 bcd | 0.46 ± 0.01 bc | 0.24 ± 0.07 d | 0.53 ± 0.01 ab | 0.69 ± 0.09 a | 0.25 ± 0.04 d | 0.49 ± 0.14 bc | NF | NF |
| E5 | Isobutyl caprylate | 0.44 ± 0.01 d | 0.47 ± 0.09 cd | 0.51 ± 0.01 cd | 0.51 ± 0.04 cd | 0.49 ± 0.05 cd | 0.63 ± 0.01 b | 0.8 ± 0.05 a | 0.55 ± 0.01 bc | 0.84 ± 0.02 a | NF | NF |
| E6 | Methyl caprate | 3.09 ± 0.02 b | 3.38 ± 0.58 b | 3.44 ± 0.2 b | 3.14 ± 0.02 b | 3.49 ± 0.27 b | 5.1 ± 0.11 a | 5.32 ± 0.01 a | 3.54 ± 0.2 b | 5.08 ± 0.08 a | NF | Wine |
| E7 | Isoamyl caprylate | 3 ± 0.04 e | 3.55 ± 0.41 cd | 3.94 ± 0.22 c | 4.78 ± 0.31 b | 3.3 ± 0.07 de | 4.67 ± 0.12 b | 6.95 ± 0.16 a | 3.49 ± 0.03 cd | 4.72 ± 0.14 b | 0.125 [40] | Fruity, cheese |
| E8 | n-Capric acid isobutyl ester | 0.21 ± 0 e | 0.29 ± 0.03 d | 0.39 ± 0 c | 0.36 ± 0.02 c | 0.22 ± 0.07 e | 0.5 ± 0.01 b | 0.56 ± 0.01 ab | 0.37 ± 0 c | 0.61 ± 0.04 a | NF | NF |
| E9 | Methyl laurate | 0.18 ± 0.01 f | 0.29 ± 0.01 de | 0.38 ± 0 c | 0.36 ± 0.07 cd | 0.23 ± 0.02 ef | 0.35 ± 0.06 cd | 0.35 ± 0.02 cd | 0.46 ± 0.01 b | 0.75 ± 0 a | NF | NF |
| E10 | Isoamyl caprate | 0.68 ± 0.07 c | 0.93 ± 0.2 c | 1.56 ± 0.23 b | 2.01 ± 0.12 b | 0.61 ± 0.2 c | 2.18 ± 0.16 ab | 2.71 ± 0.01 a | 2.05 ± 0.18 b | 2.18 ± 0.64 ab | NF | NF |
| Fatty acid | 31.74 ± 1.75 g | 35.79 ± 3.01 fg | 38.29 ± 0.34 efg | 45.23 ± 3.23 cde | 40.64 ± 1.22 def | 51.06 ± 2.96 bc | 67.07 ± 1.01 a | 52.88 ± 2.68 b | 47.19 ± 6.12 bcd | |||
| F1 | Hexanoic acid | 1.61 ± 0.09 a | 1.52 ± 0.07 ab | 1.27 ± 0.02 cd | 1.59 ± 0.18 a | 1.33 ± 0.08 bcd | 1.28 ± 0.08 cd | 1.46 ± 0.07 abc | 1.17 ± 0.04 d | 1.67 ± 0.02 a | 0.42 [19] | Cheese, foliage |
| F2 | Octanoic acid | 18.21 ± 0.58 e | 23.47 ± 2.23 d | 24.12 ± 0.35 d | 29.22 ± 3.53 bc | 27.55 ± 0.26 cd | 32.89 ± 1.55 b | 46.71 ± 0.42 a | 33.04 ± 2.88 b | 26.44 ± 1.16 cd | 0.5 [17] | Butter, almond |
| F3 | n-Capric acid | 11.91 ± 1.09 d | 10.79 ± 0.71 d | 12.91 ± 0.72 cd | 14.42 ± 0.48 bcd | 11.76 ± 1.56 d | 16.89 ± 1.33 abc | 18.9 ± 0.66 ab | 18.68 ± 0.16 ab | 19.08 ± 4.98 a | 1 [35] | Caramel, milk, fat, rotten |
| Others | 0.74 ± 0.04 c | 0.75 ± 0.02 c | 0.69 ± 0.01 de | 0.71 ± 0.02 cd | 0.64 ± 0.01 ef | 0.62 ± 0 f | 1.09 ± 0.03 b | 1.18 ± 0.03 a | 1.07 ± 0 b | |||
| G1 | Styrene | 0.13 ± 0.01 ab | 0.13 ± 0.01 ab | 0.11 ± 0.01 bc | 0.09 ± 0.01 c | 0.07 ± 0.01 c | 0.08 ± 0.01 c | 0.13 ± 0.02 ab | 0.1 ± 0.02 c | 0.15 ± 0.01 a | 0.73 [40] | NF |
| G2 | Decanal | 0.14 ± 0.01 b | 0.14 ± 0.03 b | 0.15 ± 0.01 b | 0.06 ± 0.01 c | 0.15 ± 0.07 b | 0.1 ± 0.02 bc | 0.14 ± 0 b | 0.25 ± 0.02 a | 0.28 ± 0.02 a | 0.01 [37] | NF |
| G3 | Caryophyllene | 0.2 ± 0.03 cd | 0.28 ± 0.03 bc | 0.26 ± 0.01 bcd | 0.32 ± 0.03 b | 0.22 ± 0.06 cd | 0.17 ± 0.04 d | 0.48 ± 0.05 a | 0.51 ± 0.06 a | 0.24 ± 0 bcd | NF | NF |
| G4 | Nonanal | 0.27 ± 0.02 c | 0.2 ± 0.01 e | 0.18 ± 0 e | 0.24 ± 0.01 d | 0.2 ± 0 e | 0.28 ± 0.01 c | 0.34 ± 0.01 b | 0.33 ± 0.03 b | 0.4 ± 0.01 a | 0.015 [26] | Herbaceous |
| Total | 445.75 ± 4.14 e | 510.67 ± 27.66 cd | 508.21 ± 11.92 cd | 526.1 ± 17.41 c | 500.61 ± 15.2 cd | 582.17 ± 2.3 b | 652.03 ± 8.11 a | 475.84 ± 18.11 de | 609.4 ± 9.56 b | |||
| Sum | 446.71 ± 4.19 e | 511.88 ± 27.81 cd | 510.04 ± 11.5 cd | 528.09 ± 17.04 c | 502.35 ± 15.35 cd | 583.48 ± 2.23 b | 653.61 ± 8.19 a | 477.55 ± 18.12 de | 611.38 ± 9.77 b | |||
| Sensory Features | Wine Samples | |||||||||
|---|---|---|---|---|---|---|---|---|---|---|
| CK | WSH1 | WSH10 | WCH1 | WCH10 | WSP1 | WSP10 | WCP1 | WCP10 | ||
| Color | Clarity | 5.4 ± 0.84 a | 5.8 ± 0.42 a | 5.2 ± 0.79 a | 5.6 ± 0.7 a | 5.6 ± 0.52 a | 5.7 ± 0.48 a | 5.8 ± 0.42 a | 5.6 ± 0.7 a | 5.7 ± 0.48 a |
| Chroma | 5.4 ± 0.7 a | 5.8 ± 0.42 a | 5.8 ± 0.42 a | 5.5 ± 0.53 a | 5.6 ± 0.52 a | 5.6 ± 0.52 a | 5.6 ± 0.52 a | 5.5 ± 0.53 a | 5.4 ± 0.52 a | |
| Hue | 5.2 ± 0.92 b | 5.8 ± 0.42 a | 5.4 ± 0.52 ab | 5.6 ± 0.52 ab | 5.5 ± 0.53 ab | 5.6 ± 0.52 ab | 5.4 ± 0.52 ab | 5.5 ± 0.53 ab | 5.8 ± 0.42 a | |
| Aroma | Pure Degree | 4.8 ± 0.79 c | 5.2 ± 0.63 abc | 4.2 ± 0.79 d | 5.2 ± 0.42 abc | 4.9 ± 0.32 c | 5.1 ± 0.32 bc | 5.7 ± 0.67 a | 5 ± 0.47 c | 5.6 ± 0.52 ab |
| Wine Body | 6.8 ± 0.79 ab | 7.1 ± 0.74 ab | 6.1 ± 0.57 c | 6.6 ± 0.7 bc | 6.8 ± 0.79 ab | 6.8 ± 0.63 ab | 7.4 ± 0.52 a | 7.1 ± 0.57 ab | 6.9 ± 0.74 ab | |
| Elegant | 6.8 ± 0.79 b | 6.8 ± 0.42 b | 5.9 ± 0.74 c | 6.8 ± 0.42 b | 5.6 ± 0.52 c | 7.2 ± 0.63 ab | 7.5 ± 0.53 a | 6.7 ± 0.48 b | 7.2 ± 0.63 ab | |
| Harmony | 6.4 ± 0.7 bc | 6.8 ± 0.63 b | 6 ± 0.67 c | 6.8 ± 0.42 b | 6.9 ± 0.74 b | 7 ± 0.67 ab | 7.5 ± 0.53 a | 6.8 ± 0.63 b | 6.8 ± 0.42 b | |
| Taste | Pure Degree | 4.7 ± 0.48 b | 5.3 ± 0.67 a | 5 ± 0.47 ab | 4.8 ± 0.79 ab | 5 ± 0.47 ab | 5.3 ± 0.48 a | 5.1 ± 0.57 ab | 4.9 ± 0.57 ab | 5.3 ± 0.48 a |
| Wine Body | 6.3 ± 0.82 a | 7 ± 0.47 a | 6.8 ± 0.79 a | 7 ± 0.82 a | 6.7 ± 0.67 a | 6.9 ± 0.74 a | 6.8 ± 0.79 a | 6.9 ± 0.57 a | 6.9 ± 0.57 a | |
| Structure | 6.4 ± 0.84 a | 6.4 ± 0.52 a | 6.7 ± 0.82 a | 6.7 ± 0.67 a | 6.8 ± 0.79 a | 6.8 ± 0.63 a | 6.9 ± 0.74 a | 6.6 ± 0.7 a | 6.8 ± 0.63 a | |
| Harmony | 6.4 ± 0.84 a | 6.4 ± 0.52 a | 6.5 ± 0.71 a | 6.5 ± 0.85 a | 6.7 ± 0.48 a | 6.7 ± 0.67 a | 7 ± 0.67 a | 6.6 ± 0.7 a | 7 ± 0.47 a | |
| Persistence | 6.6 ± 0.7 a | 6.4 ± 0.7 a | 6.3 ± 0.95 a | 6.6 ± 0.84 a | 6.7 ± 0.67 a | 6.6 ± 0.52 a | 6.6 ± 0.7 a | 6.7 ± 0.67 a | 6.6 ± 0.7 a | |
| Finish | 4.8 ± 0.79 a | 4.6 ± 0.52 a | 4.4 ± 0.84 a | 4.8 ± 0.42 a | 4.8 ± 0.63 a | 4.7 ± 0.48 a | 4.9 ± 0.57 a | 4.5 ± 0.53 a | 5 ± 0.47 a | |
| Comprehensive evaluation | 6.5 ± 0.53 ab | 6.8 ± 0.63 ab | 6.8 ± 0.63 ab | 6.4 ± 0.7 b | 6.6 ± 0.7 ab | 6.9 ± 0.57 ab | 7.1 ± 0.74 a | 6.7 ± 0.48 ab | 7.1 ± 0.32 a | |
| Total points | 82.5 ± 6.9 cd | 86.2 ± 3.05 abc | 81.1 ± 5.8 d | 84.9 ± 3.73 abcd | 84.2 ± 5.05 bcd | 86.9 ± 3.31 abc | 89.3 ± 3.06 a | 85.1 ± 4.25 abcd | 88.1 ± 2.92 ab | |
| Aromatic features | Melon, Fruit stem, Alcohol | Flowers, Mint, Roast toast | Yeast cell, Flowers, Oxidation | Floral, Alcohol | Floral, mint Mild oxidation | Lemon, Mint, Grapefruit | Lemon, Mint, Cream | Melo, Cream, Mint | Lemon, Mint, Almond | |
Disclaimer/Publisher’s Note: The statements, opinions and data contained in all publications are solely those of the individual author(s) and contributor(s) and not of MDPI and/or the editor(s). MDPI and/or the editor(s) disclaim responsibility for any injury to people or property resulting from any ideas, methods, instructions or products referred to in the content. |
© 2023 by the authors. Licensee MDPI, Basel, Switzerland. This article is an open access article distributed under the terms and conditions of the Creative Commons Attribution (CC BY) license (https://creativecommons.org/licenses/by/4.0/).
Share and Cite
Xia, H.; Zhang, Z.; Sun, L.; Zhang, Q.; Zhang, J. Effects of Mixed Fermentation on the Aroma Compounds of ‘Italian Riesling’ Dry White Wine in Eastern Foothill of Helan Mountain. Fermentation 2023, 9, 303. https://doi.org/10.3390/fermentation9030303
Xia H, Zhang Z, Sun L, Zhang Q, Zhang J. Effects of Mixed Fermentation on the Aroma Compounds of ‘Italian Riesling’ Dry White Wine in Eastern Foothill of Helan Mountain. Fermentation. 2023; 9(3):303. https://doi.org/10.3390/fermentation9030303
Chicago/Turabian StyleXia, Hongchuan, Zhong Zhang, Lijun Sun, Qingchen Zhang, and Junxiang Zhang. 2023. "Effects of Mixed Fermentation on the Aroma Compounds of ‘Italian Riesling’ Dry White Wine in Eastern Foothill of Helan Mountain" Fermentation 9, no. 3: 303. https://doi.org/10.3390/fermentation9030303
APA StyleXia, H., Zhang, Z., Sun, L., Zhang, Q., & Zhang, J. (2023). Effects of Mixed Fermentation on the Aroma Compounds of ‘Italian Riesling’ Dry White Wine in Eastern Foothill of Helan Mountain. Fermentation, 9(3), 303. https://doi.org/10.3390/fermentation9030303